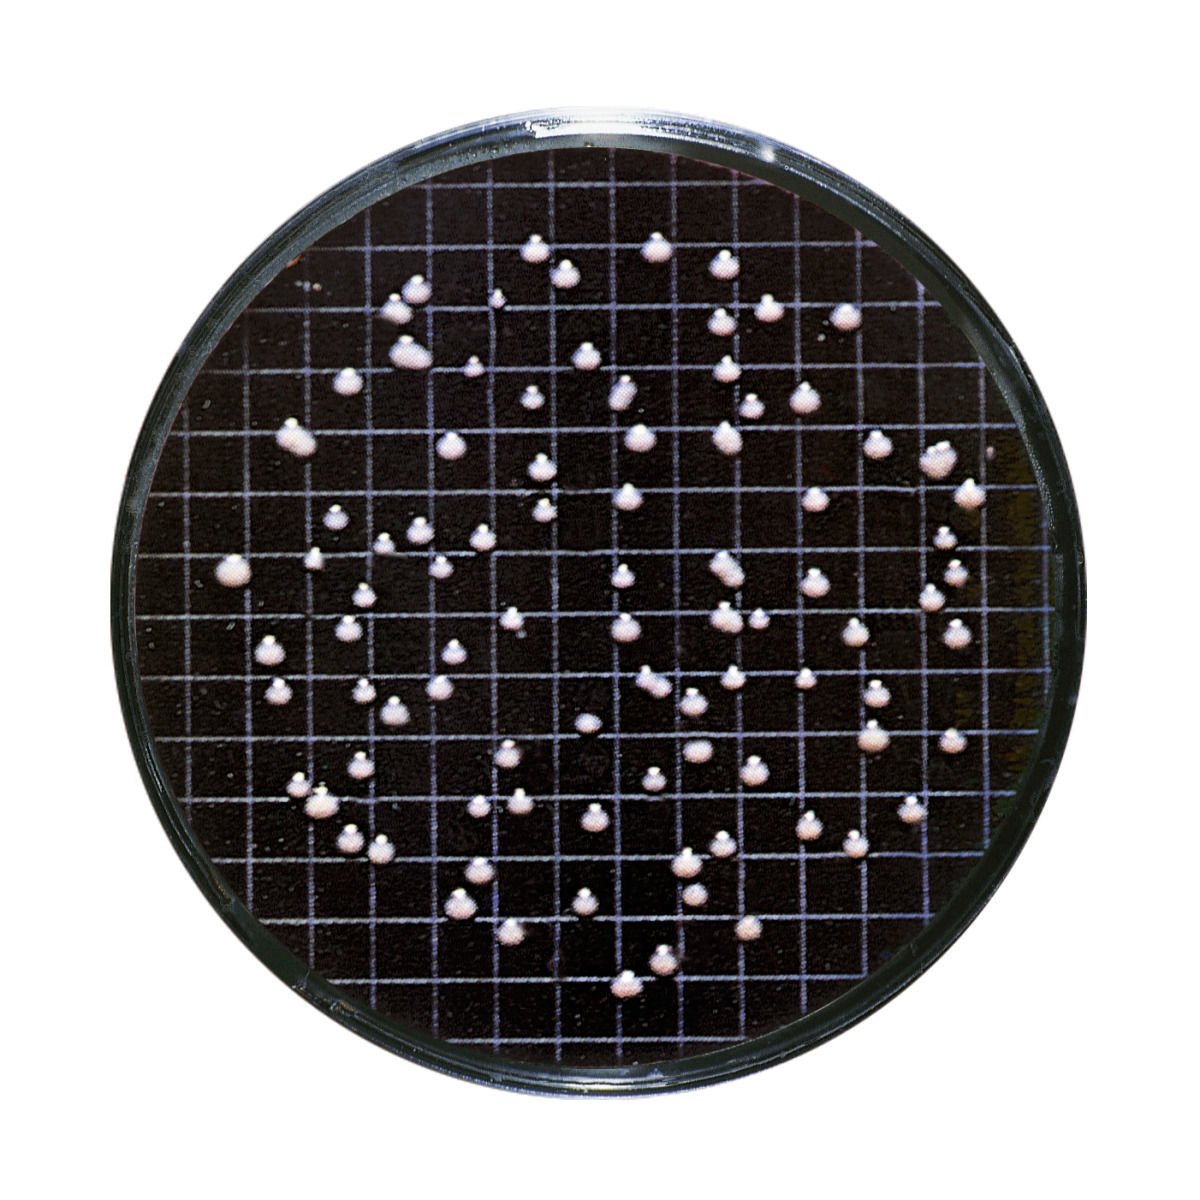

Características del Set NPS listos para usar
Los juegos de Almohadillas de Nutrientes Sartorius se han utilizado con éxito en el método de filtro de membrana por más de 30 años. Prácticos y fáciles de manejar, las Almohadillas de Nutrientes reducen el trabajo y simplifican muchos procesos de pruebas microbiológicas. Los microorganismos requieren medios de cultivo apropiados para un crecimiento óptimo. Juegos de almohadillas de nutrientes son medios de cultivo estériles y deshidratados. Una vez que se humedecen con 3,0-3,5 ml de agua estéril y desmineralizada (o puro) están listos para su uso inmediato. El nivel de humedad es óptimo cuando un exceso de anillo de agua que rodea el NPS es visible. El envase estándar de NPS contiene 100 discos nutrientes estériles, cada uno de los cuales se sitúa en una placa de petri y se esteriliza.Estas placas de petri son sellados en una bolsa de aluminio de diez unidades. Este envase en bolsas protege los componentes frágiles de los Juegos de Almohadillas de Nutrientes de las fluctuaciones de humedad y temperatura durante el transporte y almacenamiento.
Como resultado de ello, garantiza la alta calidad de nuestras fuentes de energía nuclear a lo largo de toda su vida útil de hasta 24 meses. Esto hace que los juegos de Almohadillas de Nutrientes Sartorius sean únicos: ningún otro medio de cultivo listo para uso en todo el mundo asegura tal alta calidad y resultados reproducibles, por hasta 24 meses. Cumplimiento de las Normas Internacionales: En la actualidad, Sartorius ofrece más de 30 tipos de nutrientes en juegos de almohadillas diferentes para satisfacer las diversas necesidades de análisis microbiológico. Aparte de la directiva europea de agua potable, que cumplan con otras normas y recomendaciones internacionales: Farmacopeas internacionales, estándares DIN e ISO, las normas estadounidenses para agua y alimentos, regulaciones de agua mineral, directrices de destilación como MEBAC o EBC, y recomendaciones de la industria alimentaria, tales como LMBG, NCA y ICUMSA, etc. Incluye Filtros de membrana: Todo tipo de pastillas de nutrientes se suministran con los filtros de membrana correspondientes, que son también individualmente envasados estérilmente. Juegos de almohadillas de nutrientes también están disponibles con filtros de membrana Microsart® e.motion que están especialmente diseñados para el dispensador Microsart® e.motion y puede ser convenientemente insertado. Los filtros de membrana entonces se quitan automáticamente de su envase estéril. Todos los filtros de membrana, a la medida para satisfacer las necesidades especiales de detección microbiana, están disponibles con 47 o 50 mm de diámetro.
- Se puede almacenar hasta 24 meses sin problemas
- De acuerdo con estándares y referencias internacionales
- Documentos de validación disponibles
- Altamente versátil – múltiples aplicaciones
- Económico – no consume tiempo y ni preparación en el preparado intensivo de los medios de nutrientes (esterilización, limpieza, etc.)
- Fácil manejo – sin necesidad de un equipo integral de pruebas microbiológicas
Especificaciones del los Set NPS listos para usar
| SKU | Diámetro (mm) | Material de membrana | Poro de la membrana (µm) | Medio de cultivo | Color de la membrana | Reticulado |
| 14051–47——N | 47 | CN / MCE | 0,45 | azide | verde | verde oscuro |
| 14053–47——N | 47 | CN / MCE | 0,45 | endo | blanco | verde |
| 14055–47——N | 47 | CN / MCE | 0,45 | TTC (meat extract-peptone medium) | verde | verde oscuro |
| 14058–47——N | 47 | CN / MCE | 0,65 | mosto (Brewery) | gris | blanco |
| 14069–47——N | 47 | CN / MCE | 0,65 | Sabouraud | gris | blanco |
| 14075–47——N | 47 | CN / MCE | 0,45 | Cetrimide | blanco | verde |
| 14076–47——N | 47 | CN / MCE | 0,45 | Extracto de glucosa triptona/TGE | verde | verde oscuro |
| 14080–47——N | 47 | CN / MCE | 0,8 | Schaufus Pottinger (m green yeast and mold) | gris | blanco |
| 14086–47—-CCN | 47 | CN / MCE | 0,45 | extracto de malta | gris | blanco |
| 14086–47——N | 47 | CN / MCE | 0,8 | extracto de malta | gris | blanco |